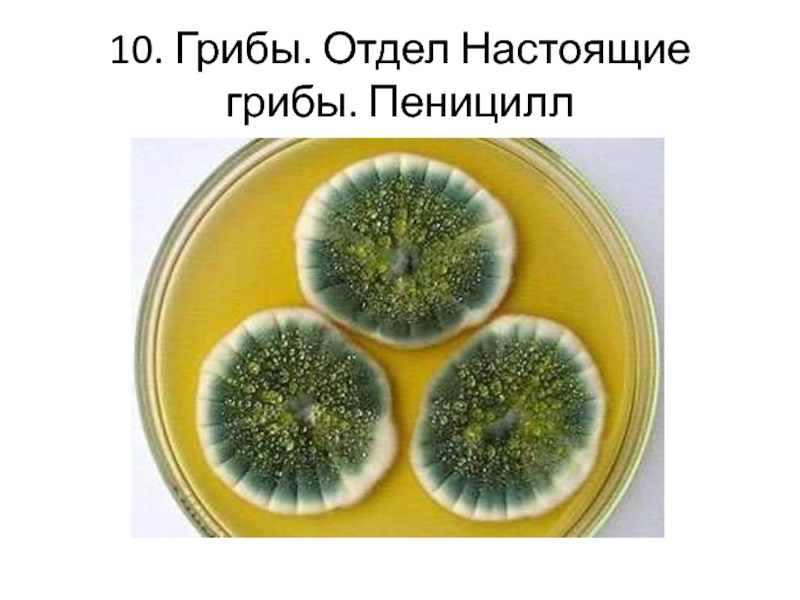

- Главная
- Разное
- Образование
- Спорт
- Естествознание
- Природоведение
- Религиоведение
- Французский язык
- Черчение
- Английский язык
- Астрономия
- Алгебра
- Биология
- География
- Геометрия
- Детские презентации
- Информатика
- История
- Литература
- Математика
- Музыка
- МХК
- Немецкий язык
- ОБЖ
- Обществознание
- Окружающий мир
- Педагогика
- Русский язык
- Технология
- Физика
- Философия
- Химия
- Шаблоны, фоны, картинки для презентаций
- Экология
- Экономика
Презентация, доклад на тему Игра-презентация по биологии Угадай царство живых организмов
Содержание
- 1. Игра-презентация по биологии Угадай царство живых организмов
- 2. В игре участвуют три царства эукариотических организмов (царство Растения, царство Животные, царство Грибы) и Лишайники
- 3. Цель игры: развитие познавательного интереса и воспитание позитивного отношения к живой природе
- 4. Правила игры: записать название царства изображенного эукариотического организма. Всего 25 изображений
- 5. 1.
- 6. 2.
- 7. 3.
- 8. 4.
- 9. 5.
- 10. 6.
- 11. 7.
- 12. 8.
- 13. 9.
- 14. 10.
- 15. 11.
- 16. 12.
- 17. 13.
- 18. 14.
- 19. 15.
- 20. 16.
- 21. 17.
- 22. 18.
- 23. 19.
- 24. 20.
- 25. 21.
- 26. 22.
- 27. 23.
- 28. 24.
- 29. 25.
- 30. Правильные ответы
- 31. 1. Лишайники. Ягель, или Олений мох – излюбленный корм северных оленей
- 32. 2. Животные. Тип Хордовые. Класс Костные рыбы. Морской дракон
- 33. 3. Растения. Отдел Бурые водоросли. Ламинария, или Морская капуста
- 34. 4. Животные. Червь Пугапорцинус, или так называемые «летающие ягодицы»
- 35. 5. Животные. Тип Кишечнополостные. Коралл-мозговик
- 36. 6. Животные. Тип Членистоногие. Усоногие раки Морские желуди
- 37. 7. Животные Тип Хордовые класс Костные рыбы Рыба-капля
- 38. 8. Животные. Тип Иглокожие. Морская лилия
- 39. 9. Растения. Отдел Папоротнико-видные. Платицериум
- 40. 10. Грибы. Отдел Настоящие грибы. Пеницилл
- 41. 11. Животные. Тип Губки. Бадяга
- 42. 12. Животные. Тип Кольчатые черви. Многощетинковый червь
- 43. 13. Грибы. Отдел Слизевики. Фулиго распадающийся
- 44. 14. Животные. Тип Плоские черви. Ресничный червь
- 45. 15. Животные. Тип Щупальцевые. Мшанка
- 46. 16. Растения. Отдел Красные водоросли. Ветвящаяся красная водоросль Литотамний
- 47. 17. Лишайники. Уснея бородатая
- 48. 18. Лишайники. Кладония пальчатая
- 49. 19. Животные. Тип Иглокожие. Морской огурец
- 50. 20. Грибы. Отдел Настоящие грибы. Веселка обыкновенная,
- 51. 21. Животные. Тип Хордовые. Асцидия
- 52. 22. Животные. Тип Членистоногие. Класс Паукообразные. Отряд Пауки. Пауки-муравьи: чтобы выжить приходится обманывать
- 53. 23. Животные. Тип Членистоногие. Класс Насекомые. Отряд Вши. Вошь лобковая
- 54. 24. Вольвокс – колониальное жгутиковое одноклеточное пресных водоемов. Это и растение, и животное одновременно
- 55. 25. Грибы. Отдел Настоящие грибы. Гриб Трихофитон вызывает грибковое заболевание стригущий лишай
- 56. Поставьте оценку: 12 (50 %) и менее
В игре участвуют три царства эукариотических организмов (царство Растения, царство Животные, царство Грибы) и Лишайники
Слайд 2В игре участвуют три царства эукариотических организмов (царство Растения, царство Животные,
царство Грибы)
и Лишайники
Слайд 3Цель игры:
развитие познавательного интереса
и
воспитание позитивного отношения к живой природе
Слайд 4Правила игры:
записать название царства изображенного эукариотического организма.
Всего 25 изображений
Слайд 5020. Грибы. Отдел Настоящие грибы. Веселка обыкновенная, или Сморчок вонючий, или
Cморчок подагрический, или Фаллюс нескромный, или срамотник.
Слайд 5222. Животные. Тип Членистоногие. Класс Паукообразные. Отряд Пауки. Пауки-муравьи: чтобы выжить
приходится обманывать
Слайд 5424. Вольвокс – колониальное жгутиковое одноклеточное пресных водоемов. Это и растение,
и животное одновременно
Слайд 5525. Грибы. Отдел Настоящие грибы.
Гриб Трихофитон вызывает грибковое заболевание стригущий лишай
Слайд 56Поставьте оценку: 12 (50 %) и менее правильных ответов – «2» 13-16 (51–65
%) – «3»
17-21 (66-85 %) – «4»
22-25 (86-100 %) – «5».